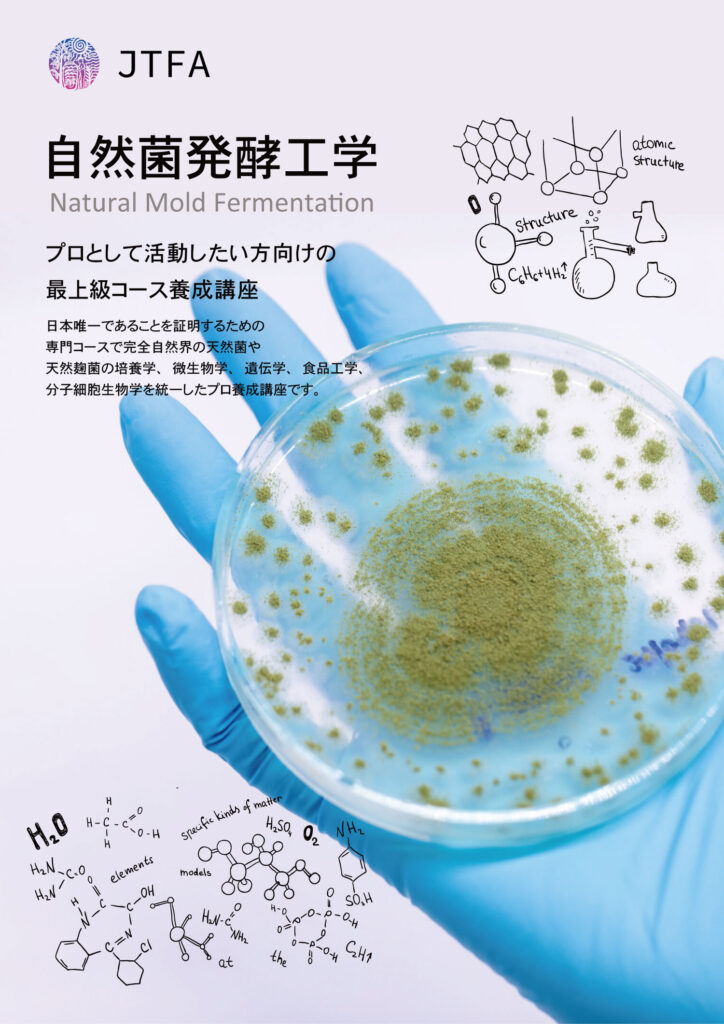

2026年度 プロ・食品発酵学スペシャリスト養成講座
モニタリング価格キャンペーン中
食品発酵を広めたいかたにおすすめ
8月26日に向けて、プロとしての志を共にする「ふさわしい方」をお待ちしております。
「天然麹学」という唯一無二の武器を手に、世界三ヶ国語で展開される専用サイトを通じて、あなたの活動をグローバルにアピールするチャンス!
これは、単なる習い事ではありません。 一生、食の主導権を握り続け、世界を相手に生き抜くための「覚悟」を学ぶ場所です。

自然界の天然かびを極める
麹や発酵を習う時に、ただ単に混ぜて仕込むだけの実践講座では根本原理や作動が理解できてないまま他の人に教える時、カビってそもそも何?と思ったことありませんか?カビの分子細胞から根本原理を学ぶ日本唯一の天然麹工学専門コースです。
科学から麹学を学ぼう!
この講座は、空気中に存在するカビの全てを理解することでオリゼー以外に数百種類のカビが存在し、食品に関わるかびを学びます。
知識のスキルを高める
オリゼーだけではなく、実際に空気中に存在する天然麹の種類を学び、培養から管理、食品に使われるところまで徹底的に学びます。
基礎からプロ級まで学ぶ
カビ学を基礎から上級レベルまで学びます。初心者も多い講座ですのでご安心ください。
人気講座

受講者からの声




560+

“受講料が高く迷いましたが、受けて良かったと思います。本当に素晴らしい講座だなぁと毎回感じています。素晴らしい講座を開いて下さってありがとうございました。"
木村
食品発酵学スペシャリストの受講者
“本当にびっくり!麹を買わなくてもいつでも天然菌で種菌が作れるからすこいなぁと思います。海外に住んでいるので麹菌が手に入らないから本当に感謝しかないです。"
中村
食品発酵学スペシャリストの受講者
金 孝錫先生のところに通い始めたのが、2021年の夏頃。 あれからちょうど3年が経ちました。 当時の私はアトピーと診断され、不安定な肌となんとか付き合っていましたが、それを治そうとして大阪に通ったわけではありません。 “食と健康”の真実が知りたいと思ったから、そして、「超絶に美味しい体が喜ぶ料理」と聞いた先生のお料理を食べてみたかったから(←こっちの理由が大きい)😆 先生のラボも現在はより整えられて、「伝統発酵アカデミー」として生徒さんもとても増えました✨✨ 正しいことを伝えようという先生の真っ当な活動が実を結んできているんだなと思います。 3年前、そこに出会えた私はラッキーだったとありがたい気持ちです🙌 この3年間で、たくさんの出会いもあって、大切なお友達もできました🤗💕 体も痒くなくなって、より健康に明るくなりました‼️ それまでデザインの仕事しかしてこなかった私ですが、伝統発酵調味料の講師として活動したり、月1レストラン営業やWSの開催などの機会を得ることもでき、幅が広がった気もします。 大学に入学する気持ちにもなりました。以前では考えもしませんでした。 伝統発酵アカデミーも、私もみんなも、全てがすごいスピードで変わっていく中で、どのタイミングで誰とご縁が結べるのか。...

Rie South
精進料理スペシャリストTeam Member
Blog & News

























